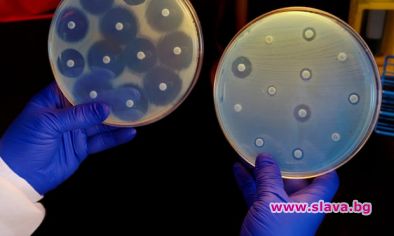

НАЙ-НОВИ
Изкуствен интелект откри нов много мощен антибиотик
24.02.2020 10:30 | Видян 1333 пъти
Джонатан Стоукс, един от главните ръководители на проучването заяви, че са необходими няколко часа, за да може алгоритъмът да анализира съединенията и да предложи някои обещаващи антибиотици. Един от тях, който изследователите нарекоха „халицин“, изглеждал особено мощен.
Тестовете на патогени, събрани от пациенти, показват, че халицинът убива Mycobacterium tuberculosis - патогенът, който причинява туберкулоза, и щамовете на Enterobacteriaceae, които са устойчиви на карбапенеми - група антибиотици, които се считат за последно средство за подобни инфекции.
Освен това халицинът лекува C. difficile и устойчиви на резистентните към много лекарства инфекции от рода на Acinetobacter baumannii при мишките.
За да открие повече повече нови лекарства, екипът се обърнал към масивна дигитална база данни с около 1,5 млрд. съединения. Те задали на алгоритъма да анализира около 107 милиона от тях, а само три дни по-късно програмата върнала кратък списък от 23 потенциални антибиотика, от които два изглеждат особено силни.
Стоукс твърди, че би било невъзможно да се анализират всички 107 милиона съединения по конвенционалния начин, а след това те да бъдат тествани в лабораторията.
„Възможността за извършване на тези експерименти дигитално драстично намалява времето и разходите за анализа на тези съединения“, каза той.
Барзилай сега иска да използва алгоритъма, за да намери антибиотици, които са по-селективни в бактериите, които убиват. Това би означавало, че приемането на антибиотика ще убива само бактериите, причиняващи инфекцията, а не всички здрави бактерии, които живеят телата ни.
„Работата на екипа е наистина забележителна и подчертава силата на компютърното откриване на нови лекарства“, заяви Джейкъб Дюрант, който работи по компютърно проектиране на лекарства в Университета в Питсбърг.
„Като се имат предвид типичните разходи за разработване на лекарства, както по отношение на времето, така и на парите, всеки метод, който може да ускори откриването на нови ефективни лекарства, има потенциал да окаже голямо влияние“, добави той.
Photograph: Science History Images/Alamy


свързани новини
Илон Мъск обяви план за обединяване на човешките мозъци с AI
коментари
- коментари
- напиши коментар
- изпрати на приятел
- гласувай
Няма коментари към тази новина !